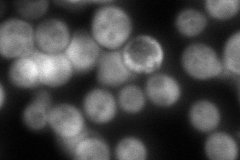
YOR184W
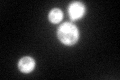
YOR184W

View description
3-phosphoserine aminotransferase, catalyzes the formation of phosphoserine from 3-phosphohydroxypyruvate, required for serine and glycine biosynthesis; regulated by the general control of amino acid biosynthesis mediated by Gcn4p
Localization:
Intensity:
Fold change:
Significance:
-
C’ GFP library in SD

cytosol161.8 -
N' NOP1pr-GFP in SD

cytosol250.011 -
N' TEF2pr-mCherry in SD

cytosol362.894 -
N' NATIVEpr-GFP in SD
cytosol215.384 -
N' TEF2pr-VC and Cyto-VN in SD

cytosol74.9726 -
C’ GFP library in SD+DTT

cytosol137.480.84No -
C’ GFP library in SD+H2O2
cytosol194.61.2No -
C’ GFP library in Starvation Media

cytosol488.233.01Yes -
C’ GFP library on the background of Pup2-DaMP

cytosol -
C’ GFP library on the background of CCT mutant

cytosol172.1351.06382No
